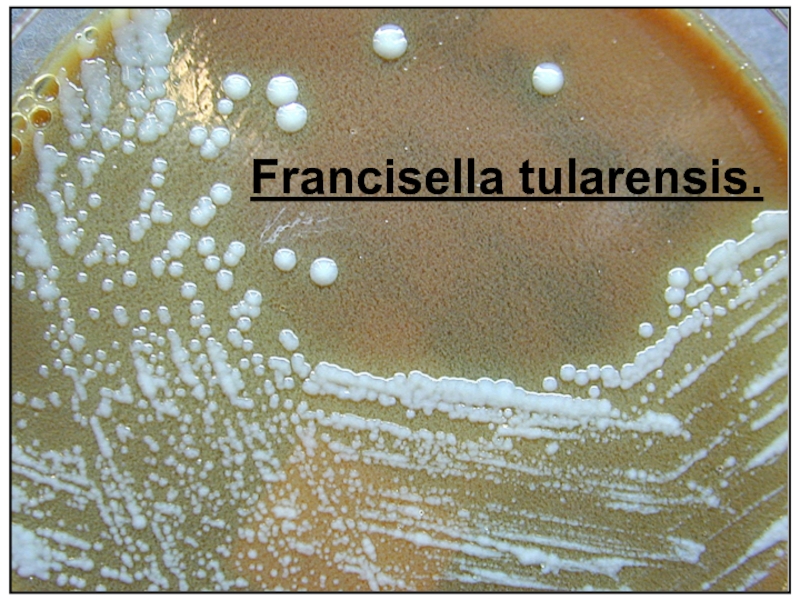

Слайд 1Тульский государственный университет
Медицинский институт
Лечебный факультет
Слайд 2Туляремия - природно-очаговое заболевание человека и животных, которое характеризуется лихорадкой,
интоксикацией и поражением лимфатических узлов.
Возбудитель туляремии отнесен к
роду Francisella,
виду F. tularensis.
Вид F. tularensis подразделяют на 3 географических подвида, отличающихся по антигенным свойствам и вирулентности:
1) голарктический (Европа, Азия, Северная Америка);
2) среднеазиатский (Средняя Азия);
3) неарктический или американский, высокопатогенный (Северная Америка).
Слайд 4Содержит соматический О- и поверхностный Vi-антигены.
Имеют антигенную близость с
бруцеллами.
В R-форме теряют Vi-антиген, а вместе с ним вирулентность
и иммуногенность.
Слайд 5Неарктический подвид обладает высокой патогенностью для человека при кожном пути
заражения.
Голарктический и среднеазиатский подвиды умеренно патогенны.
Слайд 6Вирулентными являются S-формы колоний. Патогенные свойства связаны с оболоченным антигенным
комплексом и токсическими веществами типа эндотоксина.
Возбудитель патогенен для млекопитающих
многих видов, особенно для мелких грызунов и зайцев. Из лабораторных животных к нему высокочувствительны морские свинки и белые мыши.
Слайд 7Источником инфекции являются водяные полевки,
зайцы, хомяки, ондатры, кроты, мышевидные
грызуны.
Пути передачи. Для туляремии характерна множественность механизмов заражения и
путей передачи возбудителя инфекции.
В настоящее время на территории РФ выделяют 6 основных ландшафтных типов природных очагов туляремии:
луго-полевой,
степной,
пойменно-болотный,
предгорно- (горно-)- ручьевой,
лесной,
тундровый.
Отдельно выделяют синантропные (или урбанические очаги).
Слайд 9При луго-полевом типе очага инфекция поддерживается в популяциях всех видов
полевок, зайца-русака и других млекопитающих. Резервуарами и переносчиками инфекции служат
иксодовые клещи.
Циркуляция возбудителя в степном (овражно-балочном) типе очага происходит за счет популяций видов-двойников обыкновенной полевки, степной пеструшки и домовых мышей. Активно вовлекаются в этот процесс зайцы-русаки, хомяки, общественные полевки и другие виды млекопитающих.
Резервуаром и источниками инфекции служат многочисленные виды пастбищных иксодовых клещей.
Слайд 11Пойменно-болотый тип очага (озерно-займищный, лиманно-плавневый) поддерживается водяной полевкой, ондатрой и
другими околоводными млекопитающими. Существенную роль в передаче инфекции от зверька
к зверьку, а также человеку играют комары и слепни .
В лесном типе очага инфекция поддерживается среди рыжих полевок, лесных и желтогорлых мышей, а местами – зайцами. Хранителями инфекции служат иксодовые клещи.
Слайд 12Тундровый тип очага поддерживается за счет разных видов леммингов и
других мелких грызунов. Инфекция сохраняется годами в подстилках гнезд леммингов
(на вечной мерзлоте) и во льду.
Синантропный тип очага находится на территории городов, поселков или их окраинах. Основными носителями возбудителя туляремии являются синантропные грызуны – домовая мышь и серая крыса.
Слайд 13В соответствии с разнообразием механизмов заражения людей, а также с
условиями, при которых произошло заражение, различают следующие основные эпидемиологические типы
заболеваемости людей туляремией:
1. При трансмиссивном типе заболевания заражение людей происходит через укус двукрылых (комаров, слепней). Преобладают язвенно-бубонная и бубонная формы заболевания. Заболевания чаще происходят в пойменно-болотных природных очагах во время сенокоса, охоты, рыбалки вблизи водоема в августе, сентябре месяце. Заражение людей туляремией при присасывании иксодовых клещей происходит весной и осенью в луго-полевых, реже - в лесных природных очагах.
Слайд 142. При промысловом типе заражение людей происходит при промысле водяных
полевок, хомяков, зайцев, ондатр, кротов. Механизм заражения – контактный, через
скарифицированные кожные покровы, но могут иметь место алиментарный и аспирационный механизмы заражения. Преобладает бубонная форма, реже встречается язвенно-бубонная, ангинозно-бубонная, глазо-бубонная.
3. Охотничье-пищевой тип заражения происходит во время охоты на зайцев, ондатр при снятии шкурок, разделке тушек и употреблении в пищу недостаточно обработанного термически или малосольного мяса, а также при втирании инфицированными руками возбудителя в слизистую оболочку глаза. В годы интенсивных эпизоотий у мышевидных грызунов возможны заражения охотников, ночующих в стогах сена и соломы. Преобладает бубонная, язвенно-бубонная и абдоминальная формы заболевания.
Слайд 154. Водный тип заражения людей происходит через контаминированную возбудителем воду
ручьев, открытых водоисточников, колодцев и местных водопроводов. Механизм заражения преимущественно
алиментарный, реже – контактный (купание, умывание, переход вброд, полоскание белья, полив огорода в зараженном источнике). Преобладают ангинозно-бубонная, бубонная, абдоминальная клинические формы заболевания.
Слайд 165. При сельскохозяйственном типе заражение
людей чаще всего происходит
воздушно-пылевым аэрозолем
от инфицированных больными грызунами соломы, сена, зерна при их использовании
в хозяйственных целях. Преобладает аспирационный механизм заражения
и легочная форма болезни,
реже абдоминальная и ангинозно-бубонная форма. Заражение при бытовом типе происходит через инфицированные субстраты и возникает непосредственно в быту (дома, на усадьбе).
Больные грызуны либо сами мигрируют в
населенный пункт, либо их завозят с соломой, зерном, корнеплодами.
Преобладает аспирационный механизм заражения. Заражение происходит во время подметания пола, переборке и сушке сельскохозяйственных продуктов, раздаче корма домашним животным, или при употреблении в пищу инфицированных продуктов.
Слайд 18внедрение
и
первичная
адаптация
возбудителя
лимфагенное
распространение
первичные
регионарно-
очаговые
реакции
организма
гематогенные
метастазы
и генерализация
процесса
Вторичные
очаги
реактивно-
аллергические
изменения
обратный
метаморфоз
выздоровление
ПАТОГЕНЕЗ
Возбудитель туляремии попадает в
организм человека через кожу, слизистые оболочки глаз, дыхательных путей, желудочно-кишечного тракта.
В патогенезе туляремии выделяют несколько фаз:
Слайд 19Ведущее значение в патогенезе имеет фаза лимфагенного распространения возбудителя. В
месте его внедрения нередко развивается первичный аффект с регионарным первичным
лимфаденитом. Периаденит выражен умеренно. Микроб и его токсины проникают в кровь, что приводит к бактериемии и генерализации процесса, метастазированию и развитию вторичных тулярямийных бубонов
Слайд 21Инкубационный период в среднем составляет 3-7 дней в зависимости от
дозы заражения и входных ворот инфекции. Независимо от клинической формы
для туляремии типично острое начало с познабливанием и резким повышением температуры тела до 38-400С и выше. Для начального периода характерны слабость, головная боль, головокружение, мышечные боли, особенно в поясничной области и икроножных мышцах, нарушение сна, повышенная потливость, особенно в ночные часы. Продолжительность начального периода общих клинических проявлений 2-3 дня, затем обнаруживаются признаки той или иной клинической формы.
Слайд 22Для ульцерагландулярной (язвенно-бубонной формы) характерно наличие язвочки в месте внедрения
возбудителя. Язвочка может быть не одна, чаще образуется в результате
укуса слепня, комара, при присасывании клеща. Язвочка как правило локализуется на открытых участках тела. Размер ее не превышает 5-7мм. Отделяемое язвочки серозно-гнойное, скудное, болезненность незначительная. Образование язвочки сопровождается лимфаденитом – увеличением и умеренной болезненностью лимфатических узлов. Язвочка заживает под коркой довольно медленно, в течение 2-3 недель и оставляет после отпадения корочки депигментированное пятно или уплощенный рубец.
Слайд 23Гландулярная (бубонная форма) – лимфаденит наблюдается в результате контактного заражения.
Чаще заражение происходит через кожу рук с последующим вовлечением в
воспалительный процесс группы локтевых и подмышечных лимфатических узлов. Лимфаузлы достигают максимума размеров к 5-8 дню болезни. Размеры лимфаденита могут варьировать от лесного ореха до размеров куриного яйца. Исход лимфаденита может быть различным: полное рассасывание, нагноение с последующим самопроизвольным или хирургическим вскрытием, заканчивающимся рубцеванием.
Слайд 24глазо-бубонная форма развивается в результате заражения через слизистую оболочку глаза.
Для данной формы
характерным является
острый специфический
конъюнктивит с
сильным
слезотечением,
выраженной отечностью
век до резкого
сужения глазной щели,
слизисто-гнойное отделяемое.
Специфические поражения глаз при туляремии, как правило, односторонние, сопровождающиеся воспалительной реакцией со стороны предушных и подчелюстных лимфатических узлов.
Слайд 25При легочной форме туляремии клиническая картина выражается в пневмонии (очаговой,
сегментарной, диссеминированной), бронхопневмонии, бронхите. В отдельных случаях процесс может ограничиться
трахеитом. Наиболее тяжело протекает пневмонический вариант, который характеризуется резким повышением температуры тела до 39-40ºС. Лихорадочная реакция может быть в виде двух волн, вначале сухой кашель, а затем – с небольшим количеством слизистой или слизисто-гнойной вязкой мокроты, а в последующем возможна и примесь крови. Заболевание продолжается 4-6 недель и более (до 2 месяцев) с наклонностью к рецидивам и развитию специфических осложнений (абсцессы, бронхоэктазы, плевриты). Некротизация в пораженных участках легкого может привести к образованию полостей различной величины (тулярямийные каверны).
Слайд 26Макропрепарат легкого при туляремии.
Слайд 27Желудочно-кишечная форма (абдоминальная) является результатом алиментарного заражения. В числе симптомов
для этой клинической формы характерны высокая температура тела, боли в
животе разной интенсивности и продолжительности – ноющие, схваткообразные, боли разлитые по всему животу или сосредоточенные в определенной области. Язык обложен суховатым серо-белым налетом. Характерны тошнота, рвота, метеоризм, проявления общей интоксикации. Со стороны желудочно-кишечного тракта чаще наблюдается задержка стула, но возможен и жидкий стул в начале заболевания. Описаны случаи обнаружения язв в слизистой подвздошной и толстой кишки, а также пилорической части желудка и 12-перстной кишки. Абдоминальная форма туляремии протекает более тяжело и весьма сходная клинической симптоматикой брюшного тифа.
Слайд 28Генерализованная форма (септическая) характеризуется тяжелым течением. Выражен токсикоз, иногда отмечается
потеря сознания, бред, адинамия. Наблюдаются сильные головные и мышечные боли.
Лихорадка волнообразная, продолжительностью до 3-х недель и более. На коже отмечаются высыпания, поражаются сосуды. Сыпь появляется обычно во второй половине заболевания. Нередко возникают симметричные высыпания на нижних и верхних конечностях, у некоторых больных на лице, шее, груди. Сыпь розово-красного цвета, постепенно становится багрово-медной и в последующем приобретает лиловые оттенки. Описаны «перчатки», «гетры», «носки», «воротник», «маска» - места сгущения сыпи. Держится сыпь 8-12 дней и разрешается шелушением, напоминающим скарлатину или псевдотуберкулез.
Слайд 29При ангинозно-гландулярной форме (ангинозно-бубонной) заражение происходит при употреблении продуктов, воды,
инфицированных больными грызунами, недостаточно термически обработанного мяса. Для этого клинического
варианта характерно наличие специфической ангины, а именно: гиперемия и отечность миндалин с синюшным оттенком, серовато-белые налеты. Тулярямийные ангины чаще могут быть односторонними. Одновременно с развитием ангины наблюдается увеличение, нередко до размеров куриного яйца и больше, подчелюстных, переднешейных, а иногда и надключичных лимфатических узлов. Данную форму заболевания важно дифференцировать с дифтерией.
Слайд 30Лабораторная диагностика
После перенесенной инфекпии сохраняется длительно, иногда пожизненно; развивается аллергизаиия
организма к антигенам возбудителя.
основывается, главным образом, на иммунологических методах (серо-аллергическая
диагностика) и в меньшей степени на бактериологических методах
Слайд 31Аллергический метод основан на особенностях организма человека, заболевшего или переболевшего
туляремией, отвечать местной аллергической реакцией в виде гиперемии и инфильтрата,
на введение туляремийного антигена (тулярина). У больных туляремией людей кожная аллергическая реакция становится положительной обычно с 3-5 суток болезни и сохраняется многие годы. У привитых живой вакциной также возникает аллергическая реактивность, но она развивается медленнее (через 10-15 дней после вакцинации).
Аллергический ответ у вакцинированных сохраняется 5-6 лет. Аллергическая реакция на введение антигена – это общая реакция организма, которая при развившемся инфекционном процессе может вызвать ухудшение состояния больного, а местная реакция иногда сопровождается некрозом. Поэтому в качестве диагностического приема у больных людей проба с тулярином должна применяться с осторожностью.
Слайд 34Реакция агглютинации.
Реакция пассивной гемагглютинации (РПГА)
Иммуноферментный анализ (ИФА)
Реакция иммунофлюоресценции (РИФ), прямой
метод
Слайд 35Бактериологический метод. Выделение возбудителя наиболее вероятно в течение первых 2-3
недель от начала заболевания и реже в более поздние сроки.
Материалом для исследования служат: отделяемое кожной язвы, пунктат бубона, отделяемое слизистой глаза, мазки с зева, миндалин, мокрота и др. Бактериологический метод малоэффективен, так как в организме больного туляремийные бактерии содержатся в малом количестве.
Биологическая проба является самым чувствительным способом обнаружения туляремийных бактерий в любом исследуемом материале, т.к. биопробные животные (белые мыши, морские свинки) заболевают туляремией со смертельным исходом при подкожном введении единичных бактерий.
Слайд 36В настоящее время имеется ряд антибиотиков весьма эффективных для лечения
туляремии, в частности, препаратов группы аминогликозидов. В тяжелых случаях применяют
гентамицин или амикацин. Легкой и средней тяжести туляремии применяют антибиотики группы тетрациклинов (доксициклин). Для лечения туляремии эффективен препарат широкого спектра действия – рифампицин.
В случаях затяжного течения заболевания проводят комбинированную антибиотикотерапию и вакцинотерапию с применением убитой лечебной вакцины, которая вводится различными путями в дозах от 1 до 15 млн микробных тел с интервалом 3-6 дней. Курс лечения 6-10 инъекций.
Слайд 37Проводится в направлении всех трех звеньев эпидемического процесса:
мероприятия 1-й
группы направлены на источник инфекции;
мероприятия 2-й группы— на разрыв
механизма и путей передачи;
мероприятия 3-й группы — на восприимчивый коллектив.
Слайд 38Для специфической профилактики применяют живую тулярямийную вакцину, полученную отечественными учеными
Б. Я. Эльбертом и Н. А. Гайским из штамма №
15. Вакцина обеспечивает прочный иммунитет при заражении европейским и голарктическим подвидами и эффективна против американской разновидности возбудителя. Вакцинацию проводят по эпидемическим показаниям, а также лицам, относящимся к группам риска. Допускается одновременная вакцинация против туляремии и бруцеллеза; туляремии и чумы; а также против туляремии и некоторых других инфекций.
Не специфическая профилактика такая же, как при других зоонозах, и направлена, в первую очередь, на борьбу с грызунами.
Слайд 40Лептоспироз – заболевание, которое характеризуется волнообразной лихорадкой, интоксикацией, поражением капилляров
печени, почек, ЦНС.
Возбудитель заболевания – L interrhogans относится к
семейству
Leptospiraceae
роду Leptospira и включает более 200 сероваров.
Наиболее распространенные возбудители лептоспирозов, циркулирующие в природных и хозяйственных очагах на территории Российской Федерации, а также их основные резервуары отражены в таблице.
Слайд 43Имеют сложную антигенную структуру. Содержат обшеродовой антиген белковой природы, выявляемый
в РСК, а также вариантоспецифический поверхностный антиген липополисахаридной природы, выявляемый
в реакции агглютинации.
Таксономическим критерием для лептоспир служит антигенный состав. Основным таксоном является серовар. Серовары объединены в серогруппы (насчитывается более 25 серогрупп).
Слайд 45Ферменты агрессии:
плазмокоагулаза
фибринолизин
цитотоксин
гемолизин
Слайд 46Лептоспироз – зооноз с основным резервуаром инфекции в природе среди
мелких млекопитающих (полевки, мыши, крысы), насекомоядных (ежи, землеройки). Домашние животные
(собаки, свиньи, крупный рогатый скот) приобретают значение дополнительного резервуара инфекции.
В стране ежегодно регистрируется в среднем от 1,5 до 2,5 тыс. заболеваний людей. Более половины больных приходится на Северо-Кавказский регион (Краснодарский край). Высокий уровень заболеваемости отмечается также в Республиках Адыгее и Мордовии, Калининградской, Тульской, Вологодской, Ульяновской, Пермской областях.
Слайд 47Заражение людей происходит преимущественно водным путем из инфицированных открытых водоемов,
также возможны алиментарный и контактный пути передачи.
Из внешней среды
лептоспиры проникают в организм человека через незначительные повреждения кожи и неповрежденные слизистые оболочки полости рта, желудочно-кишечного тракта, глаз, носа.
Заражение людей происходит во время сельскохозяйственных работ на садово-огородных участках, неорганизованного отдыха на природе при несоблюдении мер личной профилактики.
Слайд 48Инфекция передается человеку посредством прямого контакта с мочой инфицированных животных
или через объекты внешней среды, контаминированные мочой животных-лептоспироносителей (главным образом
через воду, почву и растения). В заболеваемости населения лептоспирозом важную роль играет и профессиональный фактор. К группам риска относятся: ветеринарные работники, зоотехники, доярки, работники мясокомбинатов, шахтеры и др.
Слайд 49Инкубационный период 7-10 дней. Болезнь протекает остро, с явлениями волнообразной
лихорадки, интоксикации. Характерны жалобы на постоянные, часто резкие боли в
мышцах, особенно икроножных, спины, затылочных и шейных. Больные часто ощущают тошноту, нередко возникает рвота. В первые дни болезни появляется одутловатость и гиперемия лица, конъюнктив, инъекция сосудов склер. На 3-6 день болезни у части больных на конечностях и туловище (на спине, груди и боковых поверхностях живота) появляется полиморфная сыпь ярко-розового цвета
Слайд 50Длительность высыпания варьирует от нескольких часов до 7-10 дней. Несколько
раньше возможно появление герпетического высыпания на губах и крыльях носа.
Мененгиальный синдром отмечается у 10-15% больных. Отмечаются боли в глазных яблоках, возбуждение. Клинически лептоспироз может протекать в 2 формах: с желтухой и без желтухи. Степень желтушности варьирует от легкой окраски кожи, склер, видимых слизистых, которая исчезает в течение 1-2 нед. В других случаях отмечается интенсивно яркая желтушность кожи, склер, слизистых – от серо-желтого до шафранно-красного, не исчезающая в течение нескольких недель.
Слайд 51Желтуха сопровождается умеренным кожным зудом. Моча приобретает темную окраску. С
появлением желтухи отмечается еще большее увеличение печени и селезенки. Прогноз
в целом, особенно при безжелтушном течении, благоприятен. При тяжелом течении лептоспироза с желтухой и выраженным гепаторенальным синдромом, геморрагическими явлениями возможны летальные исходы. Летальность колеблется от 3% до 25-40%.
Слайд 53Материалом для исследования являются:
кровь,
моча,
СМЖ,
при летальных
исходах – паренхиматозные органы, грудной и брюшной эксудат.
Слайд 54В период лептоспиремии (1-я неделя заболевания) для обнаружения лептоспир можно
использовать микроскопию цитратной крови, посев крови, ПЦР-диагностику и заражение лабораторных
животных.
С конца 1-й, начала 2-й недели в крови больных появляются специфические антитела, которые можно определить с помощью реакции микроагглютинации и лизиза (РМАЛ), иммуноферментного анализа и др. методов.
Начиная со 2-й недели, исследуют ликвор, с 3-й недели – мочу. В случае летальных исходов – паренхиматозные органы на присутствие лептоспир (микроскопия, посев, ПЦР, биопробы).
Слайд 55Используют антибиотики пенициллин, тетрациклин в сочетании с лептоспирозным гамма -
глобулином.
При прогрессирующей острой почечной недостаточности и нарастающей гиперазотемии больным
назначают проведение гемодиализа.
Слайд 56Прививки против лептоспироза населению проводят по эпидемическим показаниям при угрозе
возникновения заболеваний. Иммунизации подлежат, относящиеся к группам профессионального риска заражения.
В целях экстренной профилактики лептоспирозов лицам, подвергшимся риску заражения, назначается доксициклин:
0,1г один раз в день в течение 5 дней.
Слайд 57При попадании инфицированного материала на кожные покровы
немедленно проводится их
обработка 5%-ым раствором йода. Слизистые оболочки глаз необходимо промыть 1%-ым
раствором борной кислоты, струей воды и ввести в глаза несколько капель 1%-ного раствора азотно-кислого серебра; в нос вводят 1%-ый раствор протаргола; рот и горло прополоскать 0,05%-ным раствором марганцово-кислого калия или 1%-ным раствором борной кислоты.
Слайд 58Неспецифическая профилактика
в антропопургических очагах сводится к выявлению и лечению
животных-лептоспироносителей, строгом соблюдении санитарно-ветеринарных правил в животноводческих хозяйствах. Особое внимание
уделяют охране водоемов от загрязнения их больными животными, не разрешается строительство животноводческих помещений на берегу водоемов. Мероприятия в природных очагах сводятся к их выявлению и оздоровлению путем борьбы с дикими зверьками-лептоспироносителями.
Слайд 60Эндемический возвратный тиф (син. клещевой возвратный тиф, аргасовый клещевой боррелиоз)
— зоонозное природно-очаговое заболевание, спорадически встречающееся в отдельных субтропических, тропических
географических зонах.
Возбудителями эндемического возвратного тифа являются более 20 видов боррелий, которые относятся к семейству Spirochaetaceae, среди которых наиболее часто вызывают заболевание африканская В. duttonii и азиатская В. persica.
Слайд 61Резервуаром в природе являются грызуны, а также аргасовые клещи,
у
которых микроб передается трансовариально.
Человек заражается через укусы клешей рода
Omithodoros.
Слайд 64Инкубационный период в среднем 7—8 суток. Патогенез и клинические проявления
обоих типов возвратных тифов схожи. Попав во внутреннюю среду организма,
боррелии внедряются в клетки лимфоидно-макрофагальной системы, где размножаются и поступают в большом количестве в кровь, вызывая лихорадку (повышение температуры тела до 39-40 °С), головную боль, озноб, тремор конечностей. Первый приступ продолжается 1-5 суток. Затем температура критически снижается, оставляя чувство разбитости и мышечной боли.
Слайд 66Каждая такая атака заканчивается подъемом титра антител
Взаимодействуя с ними, боррелии образуют агрегаты,
которые нагружаются тромбоцитами, вызывая закупорку капилляров, следствием чего является нарушение кровообращения в органах.
Большая часть боррелий погибает под влиянием антител. Однако в течение инфекции антигены этих боррелий подвергаются вариации. Это связано с наличием большого набора (несколько десятков) белковых антигенов, синтез которых кодируется разными генами, часть которых периодически находится в неактивной, «молчащей» форме.
Слайд 67В результате перегруппировок
в хромосоме
происходит активация «молчащего» гена ,
появление нового антигенного варианта.
А так как антитела вырабатываются против одного антигена, то новые антигенные варианты боррелии неожиданно появляются и вызывают рецидив заболевания.
Это может повторяться от 3 до 20 раз. Последующие приступы сокращаются до 1-2 суток или даже нескольких часов.
Прогноз эндемического возвратного тифа благоприятный. Летальность при эпидемическом возвратном тифе —
не более 1 %.
Слайд 68Иммунитет к эпидемическому возвратному тифу гуморальный, непродолжительный. В эндемических очагах
коренное население к возбудителю эндемического возвратного тифа, циркулирующему в очаге,
располагает иммунитетом.
Слайд 69Используют бактериоскопический метод — обнаружение возбудителя в толстой капле крови,
взятой на высоте лихорадочной реакции, окрашенной по Романовскому—Гимзе.
Также используют
дополнительные бактериоскопические исследования: микроскопия в темном поле «висячей капли» крови и негативный метод Бурри, состоящий в просмотре исследуемой капли крови, смешанной с тушью, серебрение боррелии в мазках крови или мазках-отпечатках из органов.
Слайд 71Биопробу ставят для дифференциации В. Recurrentis от возбудителей эндемического возвратного
тифа: морские свинки легко заражаются возбудителями клещевого возвратного тифа, а
белые мыши и крысы — В. recurrentis.
В качестве вспомогательного используют серологический метод постановкой РСК.
Слайд 72Лечение.
Применяют антибиотики тетрациклинового ряда, левомицетин, ампициллин.
Профилактика.
Специфическая профилактика не
проводится.
Не специфическая профилактика сводится к борьбе с завшивленностью населения,
в эндемических очагах с клещами и грызунами.